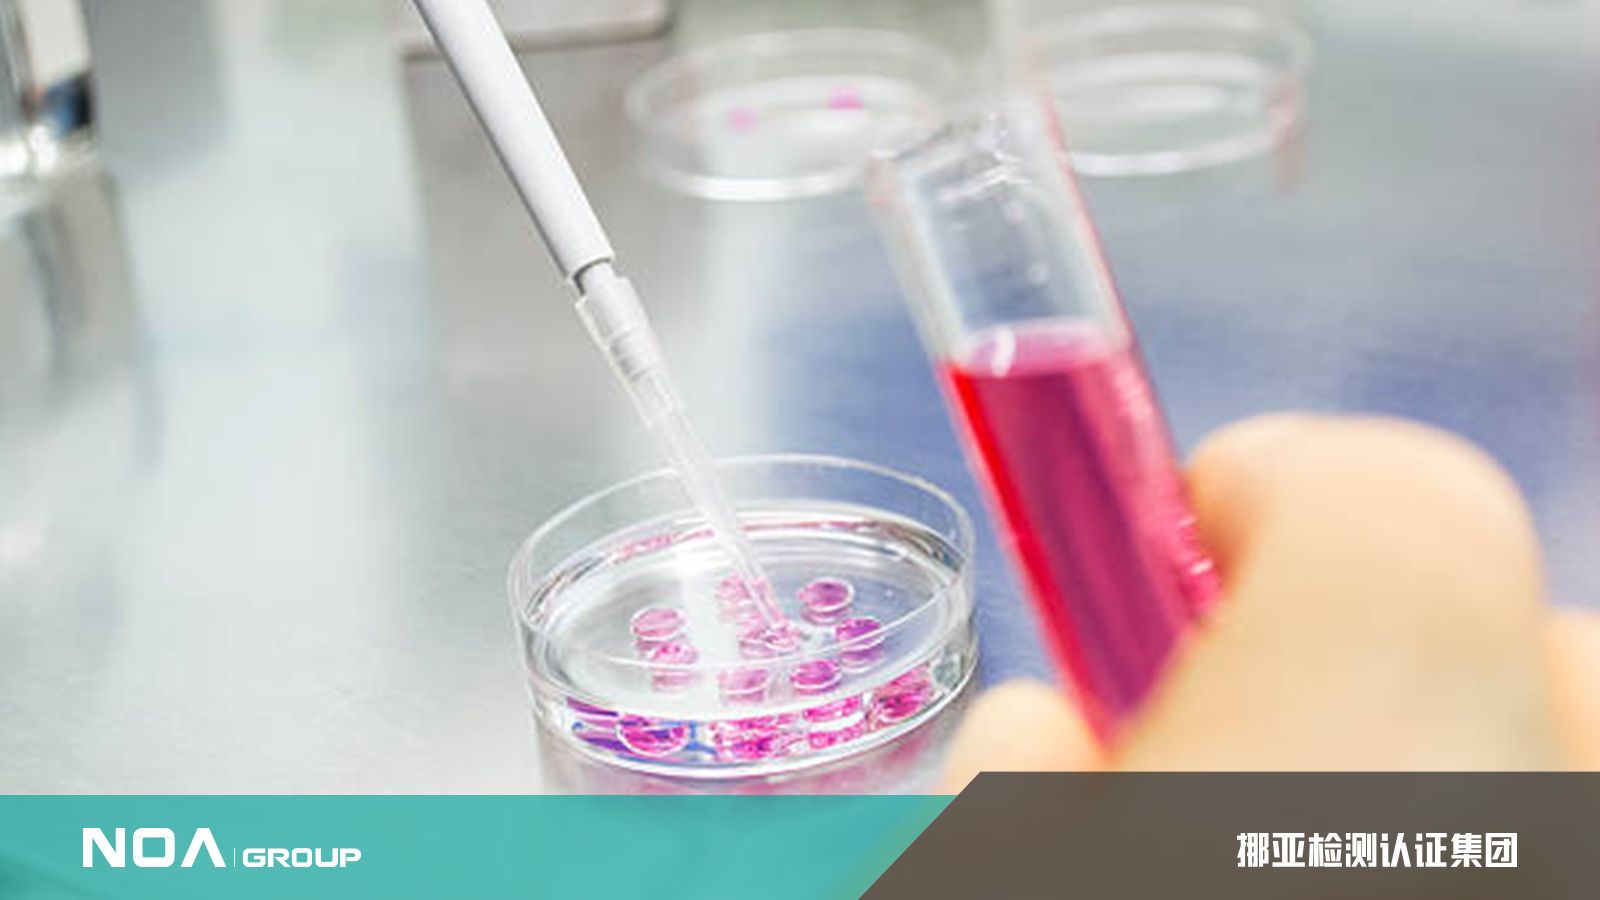

国家认可意味着机构符合并拥有行业资质及过硬的检测实力,挪亚第三方检测则具备优秀的检测能力与资质。如今在法律法规的监查下,拥有检测检验活动资质与许可是重要的前提条件;未取得资质与许可的机构,则不允许从事或提供相关的检验检测活动。挪亚检测专家评论道,社会的产物需求是决定检测市场发展的基本前提。
各国政府和机构通过不断加强对这些领域的立法、制定各种产品标准以满足社会需求;而挪亚检测,即通过对这些领域各种产品的技术验证,告知使用者是否符合法律、法规的要求,或是否符合一定的标准。

目前上海第三方检测行业市场规模还在持续增长,而检测行业是随着社会的进步而发展,基于全社会对使用产品的质量、对生活健康水平、对生产生活的安全性、对社会环境保护等方面要求的不断提高,并随着检测技术的不断进步而逐渐发展起来的行业。
在一定程度上龙头企业可以凭借规模优势,可决定是否利用广泛的渠道布局和丰富的产品线,最大程度的将已建立起来的品牌公信力充分转化为盈利能力。挪亚检测机构的服务范围包括第三方检验、设备监造、工程监理及项目管理、新能源检测、计量校准、消费品检测、金属材料及无损检测、环境检测、人体功效实验、电子电器检测、非标化学分析以及医药研发、检测分析等。挪亚拥有综合研发中心,服务于产品的成分研究、生产工艺优化与创新研发。
第三方检测机构的规模是根据客户数量、设备投资与服务类型来进行划分,挪亚检测拥有广泛的服务类别,与持续稳定增长的检测优势。一般而言,重资产的检测属性需具备专业的实验室与检测设备,挪亚检测不仅具备重资产属性,还配备专业的研究团队与丰富的检测资源,为客户进行一对一指导,做到可真正贴合企业的一站式检测服务,帮客户打破行业技术壁垒。




网友评论
最新评论